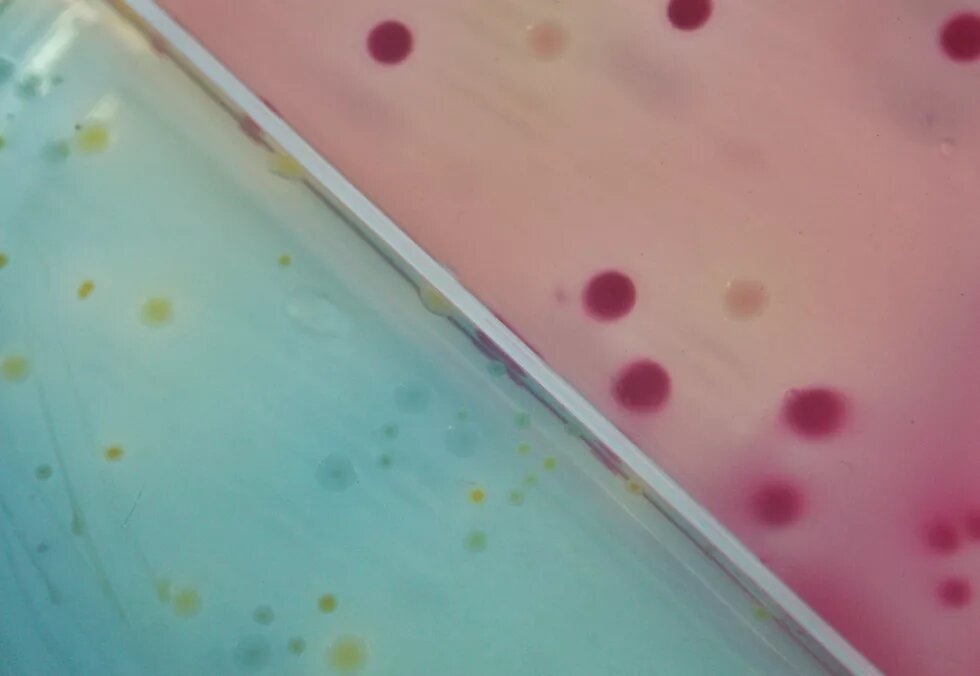

„Man kann nicht den Hersteller des Gewehres schuldig sprechen, das den Präsidenten tötet.“ Das soll Frederick Fieser auf die Frage nach seiner Schuld geantwortet haben. Fieser gilt als der Erfinder des Napalm. Er habe im zweiten Weltkrieg ein technisches Problem bearbeitet, das als dringend betrachtet wurde. Er fühle sich frei von jeder Schuld und würde das Napalm wieder entwickeln, wenn es sein Land von ihm verlange. Wie seine Entwicklung angewendet werde, liege nicht mehr in seiner Verantwortung.
Das war und ist eine Position, die in der Frage nach der gesellschaftlichen Verantwortung von Wissenschaft und Technik immer wieder auftaucht. Lange Zeit herrschte in Wissenschaft und Gesellschaft ein ungebremster Fortschrittsglaube, erklärt Regine Kollek, Professorin für Technikfolgenabschätzung an der Universität Hamburg. Wenn eine technische Entwicklung problematisiert wurde, dann im Wesentlichen vor dem Hintergrund eines Versagens der Technik. Dieses Versagen implizierte jedoch nur eine weitere Verbesserung und Optimierung der Technik. Die gesellschaftlichen Folgen blieben lange Zeit unthematisiert. Das änderte sich erst, laut Kollek, als die Biologin und Wissenschaftsjournalistin Rachel Carson im Jahr 1962 das Buch „Silent Spring“ veröffentlichte, in dem die Auswirkungen des Düngemittels DDT auf das Ökosystem beschrieben wurden. Carson hatte herausgefunden, dass das Pestizid, mit dem damals großflächig die Felder gespritzt wurden, die Eierschalen vieler Vögel weicher werden ließ und deren Nachkommen dadurch häufiger starben. Das Buch wird oft als der Ausgangspunkt der amerikanischen Umweltbewegung gesehen. Im Zuge der Diskussion wurde der Einsatz von DDT letzlich verboten.
Die Debatte gilt als eine der ersten, in der die Fortschrittsfolgen kritisch und auch wissenschaftlich fundiert thematisiert wurden. Das Beispiel DDT verdeutlicht aber auch, welche Voraussetzungen der naturwissenschaflichen Wissensproduktion implizit zugrunde liegen: Die Wirksamkeit des Düngers DDT war im Labor nachgewiesen worden. Die meisten naturwissenschaftlichen Experimente finden in einem Labor-Umfeld statt, das die komplexen Relationen der Natur aufbricht und in Einzelprozesse zerteilt. Angewandt werden die Produkte dennoch in hochkomplexen Ökosystemen. Dadurch entsteht eine konstitutive Unsicherheit bei der Anwendung jenseits des Labors. Auch deshalb ist es für viele Wissenschaftler schwierig, Verantwortung für die Anwendung des erzeugten Wissens jenseits des Labors zu übernehmen.
Doch mittlerweile wird die Frage nach der Verantwortung immer dringlicher: Welche individuelle Verantwortung trägt ein Wissenschaftler? Regine Kollek verdeutlicht die Brisanz dieser Fragen anhand von Experimenten mit dem Vogelgrippe-Virus H5N1. Einer niederländischen Forschergruppe war es 2011 gelungen, das hoch letale Vogelgrippe-Virus so zu mutieren, dass es auch durch Tröpfcheninfektion übertragbar sein sollte. Sollten die Forscher nun weiter forschen – vielleicht auch um einen möglichen Impfstoff zu entwickeln? Und: Sollten sie ihre Ergebnisse veröffentlichen? Um diese Fragen entstand eine breite innerwissenschaftliche Debatte.
In der Wissenschaftstheorie gibt es darauf, laut Kollek, verschiedenen Antworten. Der Philosoph Hans Jonas plädierte in seinem Hauptwerk „Das Prinzip Verantwortung“ für einen ökologischen Imperativ: „Handle so, dass die Wirkungen deiner Handlungen verträglich sind mit der Permanenz echten menschlichen Lebens auf Erden.“ Seine Leitlinie war es bei Prognosen zu Technikfolgen, immer die schlechteste Prognose anzunehmen. Dieses Plädoyer für eine „Ethik des verantwortungsvollen Unterlassens“ war allerdings in ihrer Negativität auch umstritten. Der Physiker Hans-Peter Dürr wollte beispielsweise solche wissenschaftlichen Entscheidungen auf der Prognostizierbarkeit des eigenen Tuns und auf allgemein existierenden Wertmaßstäben basieren lassen. Die Wissenschaft müsse in Dürrs Augen auch immer für die negativen Folgen ihrer Entwicklungen zur Rechenschaft gezogen werden können.
Der Umgang mit „Wahrheitsschäden“
Der Verantwortung des Wissenschaftlers gegenüber der Gesellschaft widmet sich auch Wolfgang van den Daele, emeritierter Professor der Soziologie an der FU Berlin. Er problematisiert in seinem Vortrag allerdings einen anderen Zusammenhang: Während Kollek den Prozess beschreibt, wie Wissenschaft und Technik die Gesellschaft vor immer neue, bisher nicht diskutierte Grenzfragen stellen, geht van den Daele der Frage nach, was passiert, wenn deren Erkenntnisse den gegenwärtigen gesellschaftlichen Werten und Normen zuwiderlaufen und sie in Frage stellen. Er nennt dies „Wahrheitsschäden“ und illustriert die Folgen am Beispiel des Molekularbiologen James Watson.
Watson hatte im Jahr 2007 in einem Interview gesagt, dass Experimente gezeigt hätten, dass Schwarze weniger intelligent seien als Weiße und er sich deshalb Sorgen um die Zukunft des Kontinents Afrika mache. Daraufhin brach ein „Scherbengericht“ über ihn herein, wie es van den Daele nennt. Watson wurde von all seinen Positionen suspendiert und wurde in der wissenschaftlichen Gemeinschaft zur persona non grata.
Gibt es also auch Wissen, so van den Daele, das man lieber nicht anstreben sollte? Wie gehen Wissenschaftler und Gesellschaft mit solchem Wissen um, wenn es öffentlich geworden ist und mit den bestehenden gesellschaftlichen Normen und Werten nicht vereinbar ist? Historisch gesehen wurden dafür, laut van den Daele, verschiedene Techniken eingesetzt: Wissenschaftler versuchten sich oft damit zu schützen, dass sie behaupten, sie produzierten doch nur „objektives Wissen“, das nichts mit gesellschaftlichen Werten zu tun habe. Von der Gesellschaft wird solches gefährliche Wissen oft als „pseudowissenschaftlich“ diffamiert und somit aus dem Diskurs der „wirklichen“ Wissenschaft ausgeschlossen.
Dieser Vorwurf wurde auch gegen die Intelligenzforschung erhoben, auf die sich Watson in seiner Aussage gestützt hatte. In diesem Fall führte dies jedoch zu vermehrter Forschung zu diesem Thema. Man ist sich dort mittlerweile zumindest einig, dass es Gruppenunterschiede gibt. Allerdings sind die individuellen Unterschiede weiterhin wesentlich größer. Die Angst der Kritiker ist jedoch, dass solche genetischen Erkenntnisse zu gesellschaftlichem Rassismus führen und dass die rechtliche Gleichstellung untergraben werde, da die Gewährung von Rechten immer noch auf der unterstellten Gleichheit ihrer Mitglieder basiert. Aber all das müsse nicht unbedingt eintreten, findet van den Daele: Man könne der Gesellschaft mehr zutrauen, als die Kritiker vermuten. Das von der Wissenschaft dennoch ein Scherbengericht über Watson gefällt wurde, hatte für van den Daele eher den Grund, eine gesellschaftliche Überreaktion gegen wissenschaftliche Forschung an sich zu verhindern. Auch Regine Kollek hat schon festgestellt: Kritische Diskussionen über Technikfolgen und Wissenschaftlerverantwortung haben oft einen Unterton der grundsätzlichen Wissenschaftsfeindlichkeit. Dennoch sind die Debatten, die insbesondere auch innerwissenschaftlich geführt wurden, wichtig. Gerade die Debatten um ein mögliches Supervirus und den Fall Watson führten zu einer breiteren wissenschaftlichen Auseinandersetzung zu den Grenzen der Forschung und zur Verantwortung von Wissenschaftlern.
Letzten Endes verändern sich nur auf diese Weise auch die Diskurse. Dass ein gewisser Anteil der Intelligenz auch genetisch bedingt ist, war laut van den Daele vor dreißig Jahren nicht einmal sagbar – heute ist dieses Wissen ein normaler Bestandteil des Diskurses. Früher war es, laut Kollek, fast schon ehrenrührig die Folgen von technischen Entwicklungen zu thematisieren und zu kritisieren – heute ist es ein eigener Wissenschaftszweig. Es setzt sich zudem auch immer mehr die Erkenntnis durch, dass in modernen Gesellschaften die Frage, was von der Wissenschaft entwickelt und hergestellt werden sollte und was nicht, nicht mehr nur innerwissenschaftlich zu beantworten ist, sondern vielmehr auch politische und gesellschaftliche Debatten erfordert.